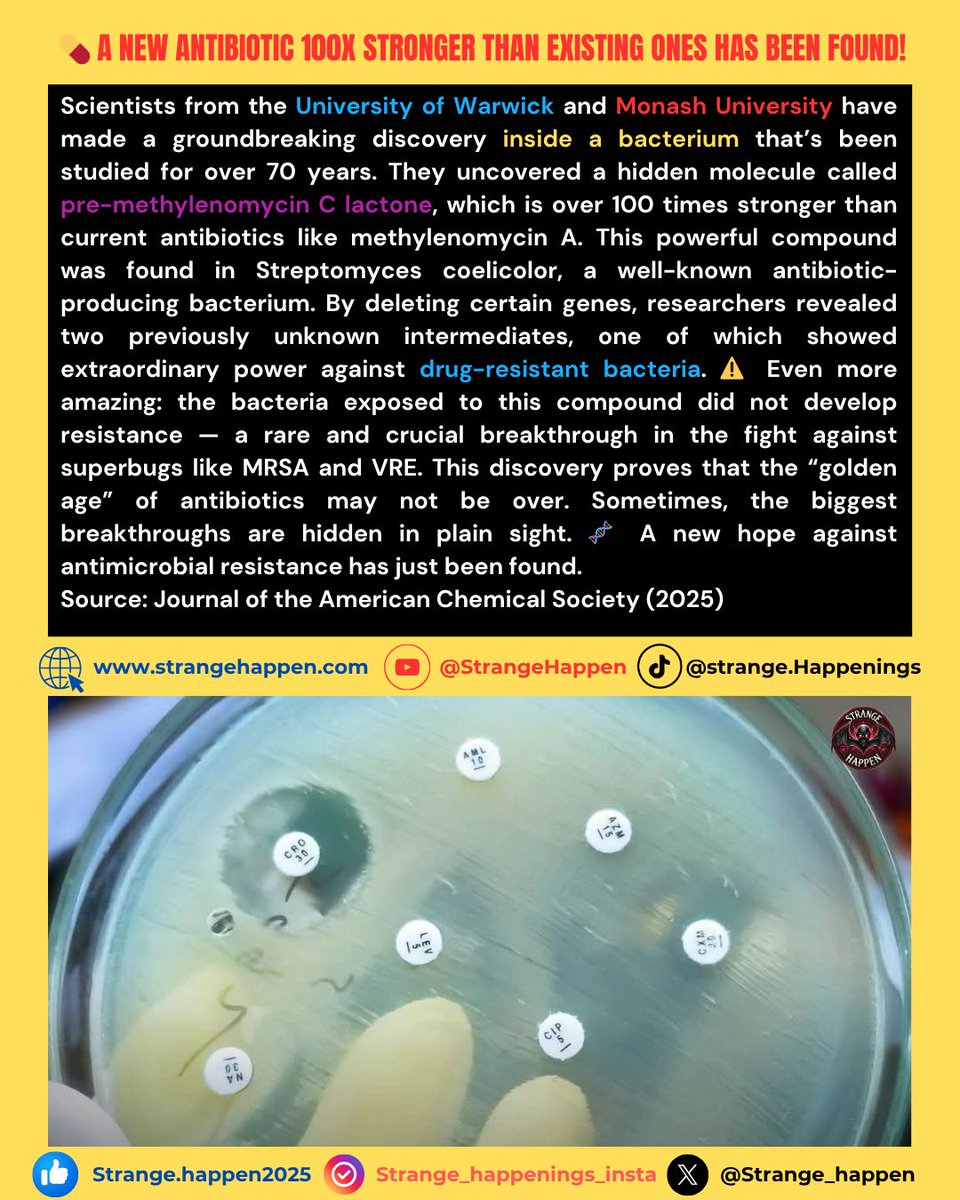
Strange Happenings tweet media

🌋 Ethiopia Volcano Eruption 2025! Hayli Gubbi awakens after 12,000 years! Ash clouds reach Yemen, Oman, and Pakistan. Stay safe and updated! 📷
strangehappen.com
#EthiopiaVolcano #EthiopiaAshCloud #trending #viralpost #trendingnow #Volcano #Ethiopia #hayligubbi

English